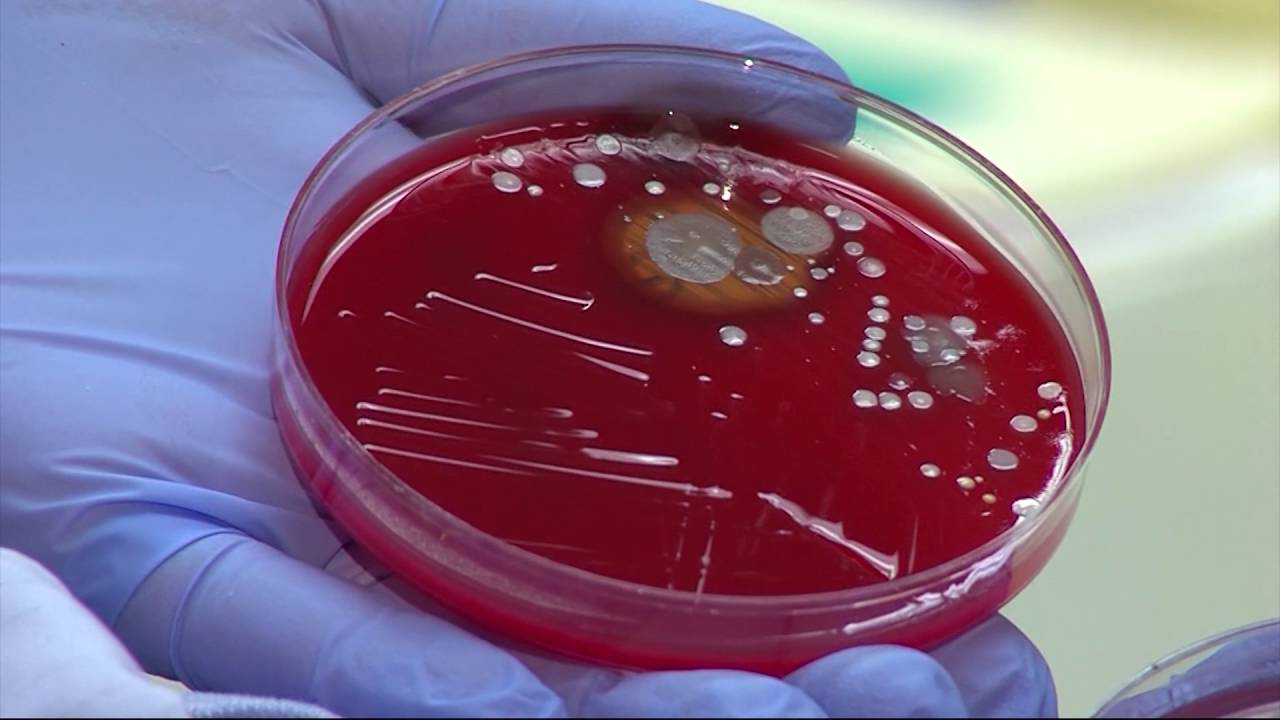
Испытайте: телефонное мыло

UVC petri dish disinfection test
Автор: Gadget Addict
Загружено: 2021-10-22
Просмотров: 2192
Have you been the victim of this UV sanitizing wand?
Many sellers are claiming it’s a UVC wand that can disinfect or sanitize your items in as little as 10 seconds.
But in our testing, we discovered the wand is actually using UVA LEDs and it does not provide the promised germicidal or disinfecting properties.
Several thousand of these wands have been sold through popular shopping websites. Some of the reviews even come from people working in hospitals!
Imagine being a frontliner in the healthcare sector, thinking you’re disinfecting your mask, P P E and other equipment, with this wand. But actually it’s doing nothing!
Reminder: you should not expose your skin or eyes to UVC

Доступные форматы для скачивания:
Скачать видео mp4
-
Информация по загрузке: